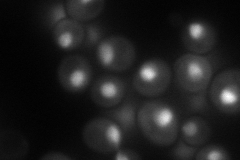
YHR189W
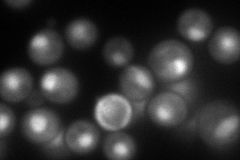
YHR189W
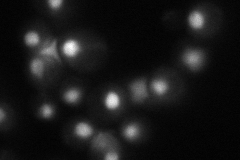
YHR189W
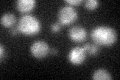
YHR189W
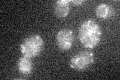
YHR189W

View description
One of two (see also PTH2) mitochondrially-localized peptidyl-tRNA hydrolases; dispensable for respiratory growth on rich medium, but required for respiratory growth on minimal medium
Localization:
Intensity:
Fold change:
Significance:
-
C’ GFP library in SD

mitochondria17.57 -
N' NOP1pr-GFP in SD
nucleus103.59 -
N' TEF2pr-mCherry in SD
nucleus116.523 -
N' NATIVEpr-GFP in SD
nucleus68.6218 -
N' TEF2pr-VC and Cyto-VN in SD

#N/A0 -
C’ GFP library in SD+DTT
mitochondria17.450.99No -
C’ GFP library in SD+H2O2

mitochondria19.461.1No -
C’ GFP library in Starvation Media
mitochondria18.031.02No -
C’ GFP library on the background of Pup2-DaMP

mitochondria -
C’ GFP library on the background of CCT mutant

mitochondria16.73180.951934No
